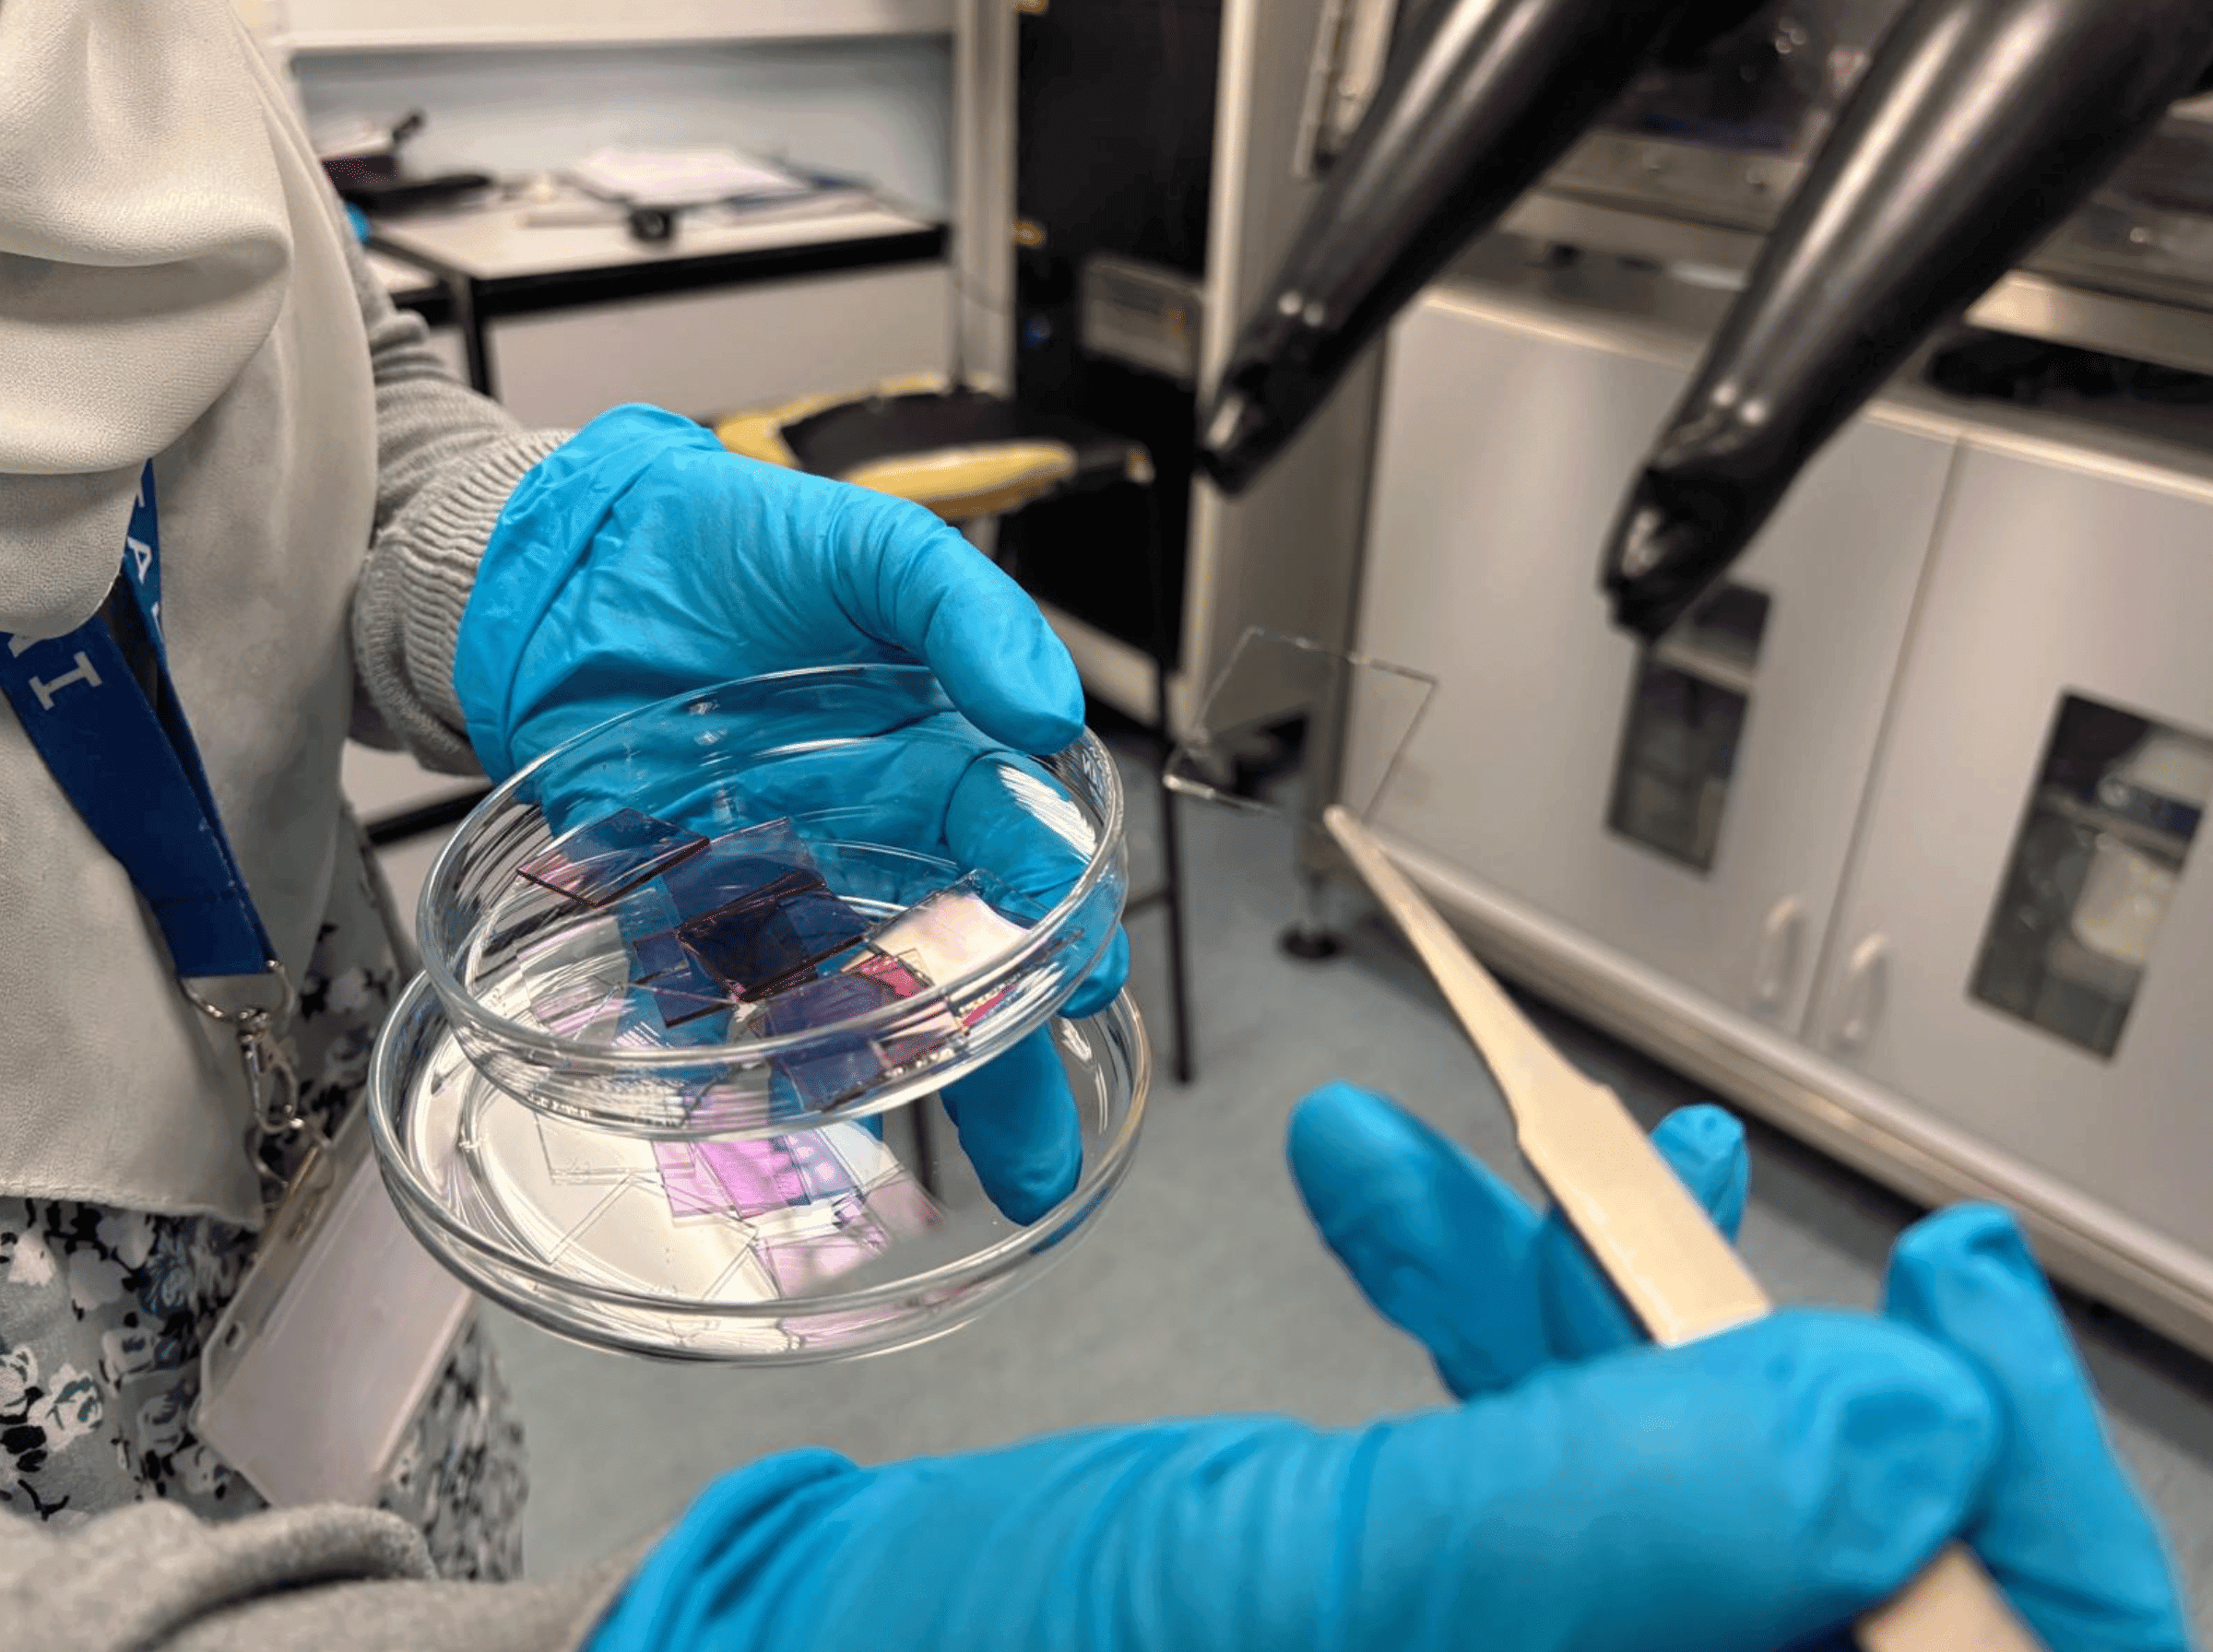

Assumption Mapping

Developing Hibearnate, we identified a range of assumptions that could lead to failure, namely:






Technical Feasibility
- Transparent-to-black smart film can be purchased or manufactured at scale.






Installation Friction
- Film installation is simple and intuitive for users.








Commercial Viability
- Consumers view light pollution as a serious sleep issue and are willing to pay to solve it.
Technical Feasibility
Transparent-to-black smart film can be purchased or manufactured at scale.

Supplier Investigation


Vertical Integration


Feasibility Validated

Supplier Investigation
We focused supplier research in Chinese-language to reduce pricing upcharges to English speaking customers. We analysed a range of suppliers, ensuring that they could send us live videos of their products so we could assess quality.
A test order of 2 test sheets: (10 x 16cm) and 2 larger form sheets (1m x 1.5m) from Wuhan Gani was ordered for $151.94 (DDP to W6 UK).
Unfortunately, the delivered sample was tinted rather than transparent-to-black and so unsuitable.



Next we contacted Gentex, a US-based manufacturer of SPD film for aerospace and automotive applications, but confirmed in a meeting with Daryl Wiseman that we did not meet their MOQs and that their film must currently be sandwiched between glass, as it remains in the pilot stage.
We also contacted a Chinese manufacturer developing a new DLC film with strong transparent-to-blackout test results, but they confirmed it is not yet ready for mass-scale production.

Academic Validation
See Appendix for full evidence!

Following unsuccessful supplier investigation we escalated the validation process to a scientific level.
First speaking to:
Jack Dawson - Kucernak Research Group
Billy Wu - Dyson school of design engineering
Sam Cooper - Dyson school of design engineering
Felix Watson - Electrical Science and Engineering Group, Imperial College London
The professors all recommended we talk to Professor Jenny Nelson,
Imperial College Physics - Electrochromic Specialist.
This process required persistence as Jenny is extremely busy but multiple meetings gave us extensive insight and, later, access to their labs.

Lab Fabrication
Visiting the lab.
Learning about testing processes alongside Dr Enas Abd Elghafar


Our execution plan.
Detailing equipment and processes to make a sample
Finished Sample.
Showing the fully transparent material with blackout coating
See 'Manufacturing Facility' in P&L!

Following the lab visit, we identified and collated the key tools and processes required to produce electrochromic samples in-house, this enabled us to outline the minimum viable lab and commercial manufacturing setup.
Developing this capability in-house creates an opportunity for Hibearnate to establish a first-mover manufacturing base in the UK for this type of electrochromic film.
Rather than relying entirely on off-the-shelf smart glass suppliers, Hibearnate could vertically integrate key stages of the materials and manufacturing process. This would help create a defensible technical moat while also opening the possibility of supplying specialised light-control films for applications beyond the initial Hibearnate product.



Subtitle

So Have we Proven Technical Feasibility?

Concept Proven
The Films work as envisioned on the ITO substrates
Concept Proven
Engineering a reliable product faces quality durability hurdles
Concept Proven
Once refined, the process can scale to large sizes
The film performs as intended on ITO substrates, and the route to larger-scale manufacturing is credible. The key remaining challenge is not whether it can work, but refining the engineering and quality control needed to deliver a reliable, durable product at scale.

Technical Feasibility Validated
Installation Friction
Film installation is simple and intuitive for users.

Instruction Creation


User Testing


Feasibility Validated
If installation is perceived as complex, risky, or technically intimidating, particularly among renters, adoption will fail regardless of technical performance.
The following assumptions must hold true for adoption to succeed:
Users are willing to install Hibearnate themselves rather than requiring professional installation.
Clear visual instructions can make the installation process feel simple and approachable.
Key steps such as trimming and alignment can be performed accurately by first-time users.
A standardized kit-of-parts can support installation across different window types.If

Instruction Creation
We purchased multiple sheet-based DIY products, including vinyl wraps and screen protectors, to understand how successful consumer brands reduce installation friction. We studied their kit-of-parts, annotated their instruction manuals, and reviewed customer feedback on Reddit to identify common pain points. looked at reviews/=.

User Testing
We developed Version 1 of the Hibearnate instruction manual and assembled a proposed kit-of-parts
We conducted an internal installation simulation with 14 participants using a section of PDLC film using fair liquid as a temporary adhesive. Participants were asked to follow the instructions independently while we observed friction points. These were tested on different sized glazed windows.
User testing results:

Supplied wiping tool was insufficient. Dust and residue were not consistently removed, affecting adhesion.
Include both a dry wiping tool and a wet cleaning wipe to ensure proper surface preparation

Participants weren't comfortable using the blade - this resulted in minor surface scratching.
A blade softer than glass but harder than the film was selected to prevent scratching.

Alignment was inconsistent when the film size didn’t match the window dimensions (too large or too small).
We conducted research into common UK residential window dimensions and identified three dominant size categories.
A/B Instruction Manual Testing:
Following the product and sizing refinements, we developed two revised instruction manual versions (Version A and Version B). Each participant received identical materials but only one manual version. Installation time, observed confusion points, and verbal feedback were recorded.

Participants reported clearer sequencing, improved confidence during alignment, and less hesitation at the trimming stage.

Learning
Through iterative testing, we refined the kit-of-parts, standardised SKU sizing based on common UK window dimensions, and optimised the instruction manual. We found that installation friction was driven not only by instructional clarity but also by tool design and dimensional ambiguity. Improving visual hierarchy, simplifying trimming tools, and pre-defining sheet sizes significantly reduced hesitation and increased completion consistency.




See final instruction manual above.

Installation Friction Validated
Commercial Viability

Sleep Test


Price Analysis


Marketing Exploration


Feasibility Validated
Consumers view light pollution as a serious sleep issue and are willing to pay to solve it.

Sleep Test
We ran a small 14-day test to explore whether reducing bedroom light pollution might affect sleep. Four family members between us tracked their sleep using Garmin watches. Participants recorded baseline sleep data for one week, followed by a week with a blackout shrink-wrap installed on their bedroom windows.
Metrics included REM %, sleep efficiency, and HRV. Results were mixed:
two participants showed no noticeable change
one showed minor improvement
one experienced a significant improvement.
While the sample size is too small to draw conclusions, the participant with the largest improvement also had the most light-polluted bedroom, which we found interesting. We recognise that this test was too small, too short and too many external factors but provides a base for potential future investigation. It is important that our aims align with ASA standards who are currently very strict on health-based advertising in the UK.

Literature Review
Although the quantitative data from our participants was inconclusive, we also asked them about their subjective sleep experience. All four reported that their sleep felt improved during the blackout period - they found it easier to fall asleep and generally felt more rested and energized in the morning. However, because the participants were friends and family members, their feedback could be biased (as highlighted in The Mom Test approach to user research). To avoid relying solely on this feedback, we conducted a short literature review to understand what existing research says about light pollution and sleep and what consumers are doing about it. This is what we found
How bad is light pollution for sleep?
Research shows that artificial light at night can disrupt sleep and circadian rhythms. Large studies have found that higher outdoor light increases the risk of sleep and mood disorders, raises the odds of sleeping less than 7 hours, and increases insomnia. Even moderate light at night can alter heart rate, metabolism, and suppress melatonin, which is key for restful sleep.
higher risk of mood and sleep disorders
Increase in hr from minimal light
What do consumers think about it?
Many people recognize poor sleep as a serious issue, often linked to exposure to artificial light at night. Light pollution is increasingly seen as a major factor disrupting sleep quality, making it harder to fall asleep and feel rested.
Consider poor sleep a serious health issue
Adults get less than 7 hours of sleep
What are consumers doing about it?
Many consumers are actively seeking solutions to improve their sleep, investing in products, habits, and technologies aimed at better sleep quality. From purchasing sleep‑focused devices to changing bedroom environments and routines, people are willing to spend money and make lifestyle changes to tackle sleep issues.
Bought a sleep related product in the last year
adults spent
$100–$500 on sleep‑improvement
Are willing to purchase a product to improve their sleep
Conclusion
After seeing these results, we believed we had validated that our product occupies a commercially viable space - one that can improve sleep while addressing a clear consumer willingness to spend on sleep solutions. We then decided to conduct more specific research to determine whether consumers are willing to buy our product.

Price Analysis
We tested whether consumers would accept a premium price point that still delivers a sustainable margin above COGS by running a Van Westendorp price sensitivity survey with 100 participants on Prolific. Participants identified thresholds for “too cheap,” “cheap,” “not expensive,” “not cheap,” “expensive,” and “too expensive,” allowing us to capture price perceptions and willingness to pay, and use real market feedback to inform an optimal pricing strategy. The survey was useful however some participants struggled, with one response being that the 'Too Expensive' price point would be 'lamp' expensive - perhaps indicating that instructions require fine-tuning.

£80-170
Acceptable Price Range
£130
Optimal Price point
£23.18
Small
£40.90
Medium
£52.59
Large
Taking a conservative view and assuming £130 as the optimal price for the Large window, and an average order value of 2x SKU RRP to reflect the average of two windows per room, this results in a projected CM1 of 59.54%.
This indicates that perceived acceptable pricing exceeds cost base sufficiently to support marketing and scaling costs. However, this reflects stated willingness, not observed purchasing behaviour. Real conversion validation is required. Next step: deposit-based pre-order test.

Marketing Exploration
Channels Tested

Reals, Posts, Stories, Ads

TikTok
Ads

Ads

Billboards
Digital Billboards

Physical
Flyers, Door-to-door
We wanted to test whether Hibearnate could generate early-stage attention through organic short-form content. This extensive testing featured a range of primary and secondary investigation, reals, posts, Tiktoks, billboards and in-person ads. We performed A/B messaging and content testing and informed implied customer acquisition costs as low as £20.56. A/B testing involved testing traction against different demographics, the demographic that yielded the best results was 18-25 UK based tech following users, whose demographic generated over 70k views on an instagram video in a single day.
For extensive breakdown of this process see P&L-'Sales & Marketing' and 'GTM' page. Snippet below:
Using the strongest-performing content identified in the A/B messaging test, we deployed paid ads with a cost of £20 over two days to test acquisition cost viability.

Ads were run across Meta platforms and we got the following results:
Cost per view
£0.25
Cost per click
Cost per waitlist signup
We then modelled estimated CAC under a 10% waitlist-to-paid conversion assumption (validation, see P&L). This estimated CAC remained below projected CM1 per unit of £20.3, indicating potential commercial viability under moderate conversion assumptions. See GTM section for more information.



















































